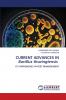
CURRENT ADVANCES IN Bacillus thuringiensis

English
Paperback
₹5541
₹7298
24.08% OFF
(All inclusive*)
Delivery Options
Please enter pincode to check delivery time.
*COD & Shipping Charges may apply on certain items.
Review final details at checkout.
Looking to place a bulk order? SUBMIT DETAILS
About The Book
Description
Author(s)
Bacillus thuringiensis (B.t.) is a gram-positive soil bacterium used as one of the entomopathogen to manage lepidopteran pests in field as well as in horticultural crop pests. The various formulation of B.t. were successfully used to protect the environment and foods from the contamination of chemical pesticide residues in pest management. The discovery of B.t. toxins with novel insecticidal activity against pests and the development of genetically modified plants opened a new era of pest management. Transgenic B.t. crops including maize cotton and soya bean have now been produced and commercialized to protect crops against about 30 major coleopteran and lepidopteran pests greatly benefiting the environment and the economy. However with the long-term cultivation of B.t. crops some target pests have gradually developed resistance. Numerous studies have indicated that mutations in genes for toxins activation toxin-binding and insect immunization are important sources in B.t. resistance. An in-depth exploration of the corresponding B.t. resistance mechanisms will aid in the design of new strategies to prevent and management of pests.
Delivery Options
Please enter pincode to check delivery time.
*COD & Shipping Charges may apply on certain items.
Review final details at checkout.
Details
ISBN 13
9786208443368
Publication Date
-22-04-2025
Pages
-88
Weight
-132 grams
Dimensions
-152x229x5.35 mm